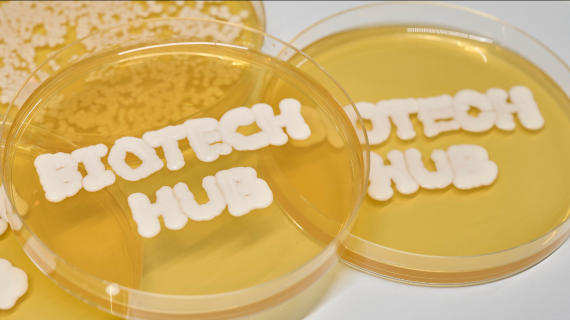

We Are Where Our Customers Are
Explore our global footprint dedicated to "Improving Quality of Life" worldwide. With commercial activities and manufacturing facilities in all main markets and regions, we are committed to being a reliable partner for our customers and an employer of choice.
Our expansive global network provides us with unique insights and perspectives, shaping our approach to creating meaningful impact. Across all our locations, we are united by our ONE GELITA culture, fostering collaboration and innovation in our pursuit of excellence.